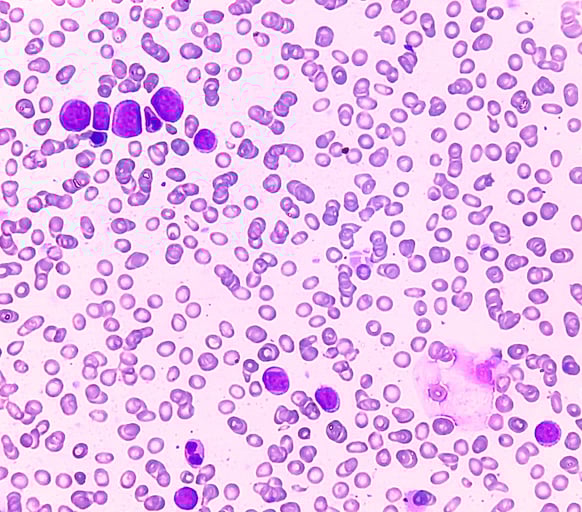

Un'arma in più contro la leucemia mieloide acuta caratterizzata dalla mutazione FLT3-ITD. Anche in Italia è stato finalmente approvato da AIFA quizartinib, un farmaco mirato destinato ai pazienti adulti affetti da questa particolare forma di malattia. Un'opzione in più che va ad integrarsi alla chemioterapia, strategia già ampiamente utilizzata con successo.
UNA MALATTIA, DIVERSE MUTAZIONI
La leucemia mieloide acuta è un tumore del sangue che ogni anno, in Italia, fa registrare circa 2 mila nuovi diagnosi prevalentemente intorno ai 70 anni di età. Come spesso sta sempre più accadendo in molti tumori, oggi la classificazione della malattia passa soprattutto dalle alterazioni genetiche. Tra queste le mutazioni del gene FLT3 sono tra le più frequenti e, nella variante ITD, si associano a un rischio elevato di ricaduta e a una sopravvivenza più bassa.
IL RISCHIO DI RECIDIVA RIMANE ELEVATO
Per i pazienti che possono affrontare una chemioterapia intensiva, il percorso resta diviso in tre fasi: induzione, consolidamento e mantenimento. L’obiettivo è prima ottenere la remissione e poi mantenerla riducendo il rischio che la malattia ritorni. Nonostante i progressi, tra il 40% e il 50% dei pazienti va incontro a recidiva dopo il trattamento di prima linea. È qui che le terapie mirate -insieme allo sviluppo delle terapie cellulari Car-T e Car-NK- giocano un ruolo crescente perché agiscono su difetti molecolari specifici e modificano la storia naturale di alcune forme di leucemia mieloide acuta.
COLPIRE LA MUTAZIONE
Quizartinib, il farmaco da poco approvato, è stato sviluppato proprio per questa mutazione. È un inibitore orale di FLT3 che blocca la cascata di segnali su cui la cellula leucemica mutata costruisce la propria crescita. L’approvazione in Italia consentirà agli ematologi di impiegarlo fin dall’inizio del percorso terapeutico, integrandolo alla chemioterapia standard e proseguendo poi con una fase di mantenimento. La decisione delle autorità italiane si basa sui risultati dello studio internazionale QuANTUM-First, pubblicato su The Lancet nel 2023. È il primo trial a dimostrare in modo chiaro che aggiungere un inibitore FLT3-ITD al trattamento standard può cambiare la prognosi.
VIVERE A LUNGO
Nel gruppo trattato con quizartinib, la sopravvivenza globale mediana è risultata quasi doppia rispetto alla sola chemioterapia. Ciò significa che la metà dei pazienti trattati era ancora in vita a circa 32 mesi, mentre nel gruppo di controllo la stessa soglia si fermava a poco più di un anno. Un risultato importante che significa una cosa precisa: la combinazione di chemioterapia e terapia mirata aumenta in modo significativo le probabilità di controllare la malattia nel lungo periodo.